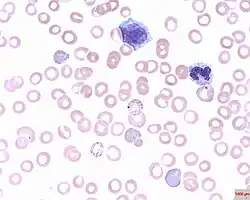

Basophilic stippling
Basophilic stippling, also known as punctate basophilia, is the presence of numerous basophilic granules that are dispersed through the cytoplasm of erythrocytes in a peripheral blood smear. They can be demonstrated to be RNA. They are composed of aggregates of ribosomes; degenerating mitochondria and siderosomes may be included in the aggregates. In contrast to Pappenheimer bodies, they are negative with Perls' acid ferrocyanide stain for iron (i.e. no iron in basophilic stippling).[1] Basophilic stippling is indicative of disturbed erythropoiesis. It can also be found in some normal individuals.[2]
Associated conditions
- Thalassemia[3] (β-thalassemia Minor (i.e. Trait) & Major, and α-thalassemia, only when 3 gene loci defective: (--/-α))
- Severe megaloblastic anemia
- Hemolytic anemia
- Sickle-cell anemia
- Pyrimidine 5' nucleotidase deficiency[4]
- Alcoholism[5]
- Myelodysplastic syndromes
- Sideroblastic anemia[6]
- Congenital dyserythropoietic anemia[7]
- Primary myelofibrosis
- Leukemia[8]
- Erythroleukemia[9]
- Hemorrhage, e.g. from gastrointestinal tract
- CPD-choline phosphotransferase deficiency[10]
- Unstable hemoglobins
- Altered hemoglobin biosynthesis
- Heavy metal poisoning[11][12]
References
- ^ Le, Tao; Bhushan, Vikas; Coleman, Caroline; Jones, Stepanie; Kaparaliotis, Panagiotis; Kallianos, Kimberly, eds. (2023). First Aid for the® USMLE® Step 1 2023 (33rd ed.). New York Chicago San Francisco: McGraw Hill. p. 422. ISBN 978-1-264-94662-4.
- ^ Cheson, B. D; Rom, W. N; Webber, R. C (1984). "Basophilic stippling of red blood cells: A nonspecific finding of multiple etiology". American Journal of Industrial Medicine. 5 (4): 327–34. doi:10.1002/ajim.4700050409. PMID 6202140.
- ^ Tkachuk, Douglas C.; Hirschmann, Jan V.; Wintrobe, Maxwell Myer (2007). Wintrobe's Atlas of Clinical Hematology. Lippincott Williams & Wilkins. ISBN 9780781770231.
- ^ Seip, M (1999). "Pyrimidine-5'-nucleotidase deficiency--congenital hemolytic anemia with basophilic stippling of erythrocytes". Tidsskrift for den Norske Laegeforening. 119 (20): 2996–8. PMID 10504847.
- ^ Chernecky, Cynthia C.; Berger, Barbara J. (2007-06-14). Laboratory Tests and Diagnostic Procedures. Elsevier Health Sciences. ISBN 978-1416066835.
- ^ Rodak, Bernadette F. (2007). Hematology : clinical principles and applications (3rd ed.). Philadelphia: Saunders. p. 535. ISBN 978-1416030065.
- ^ Kliegman, Robert M.; Stanton, Bonita M. D.; Geme, Joseph St; Schor, Nina F.; Behrman, Richard E. (2011-06-01). Nelson Textbook of Pediatrics E-Book. Elsevier Health Sciences. ISBN 978-1437735895.
- ^ Chernecky, Cynthia C.; Berger, Barbara J. (2007-06-14). Laboratory Tests and Diagnostic Procedures. Elsevier Health Sciences. ISBN 978-1416066835.
- ^ Chernecky, Cynthia C.; Berger, Barbara J. (2007-06-14). Laboratory Tests and Diagnostic Procedures. Elsevier Health Sciences. ISBN 978-1416066835.
- ^ Porwit, Anna; McCullough, Jeffrey; Erber, Wendy N. (2011-05-27). Blood and Bone Marrow Pathology E-Book. Elsevier Health Sciences. ISBN 978-0702045356.
- ^ Keohane, Elaine; Smith, Larry; Walenga, Jeanine (2015-02-19). Rodak's Hematology - E-Book: Clinical Principles and Applications. Elsevier Health Sciences. ISBN 9780323327169.
- ^ Fleisher, Gary Robert; Ludwig, Stephen; Silverman, Benjamin K. (2002). Synopsis of Pediatric Emergency Medicine. Lippincott Williams & Wilkins. ISBN 9780781732741.